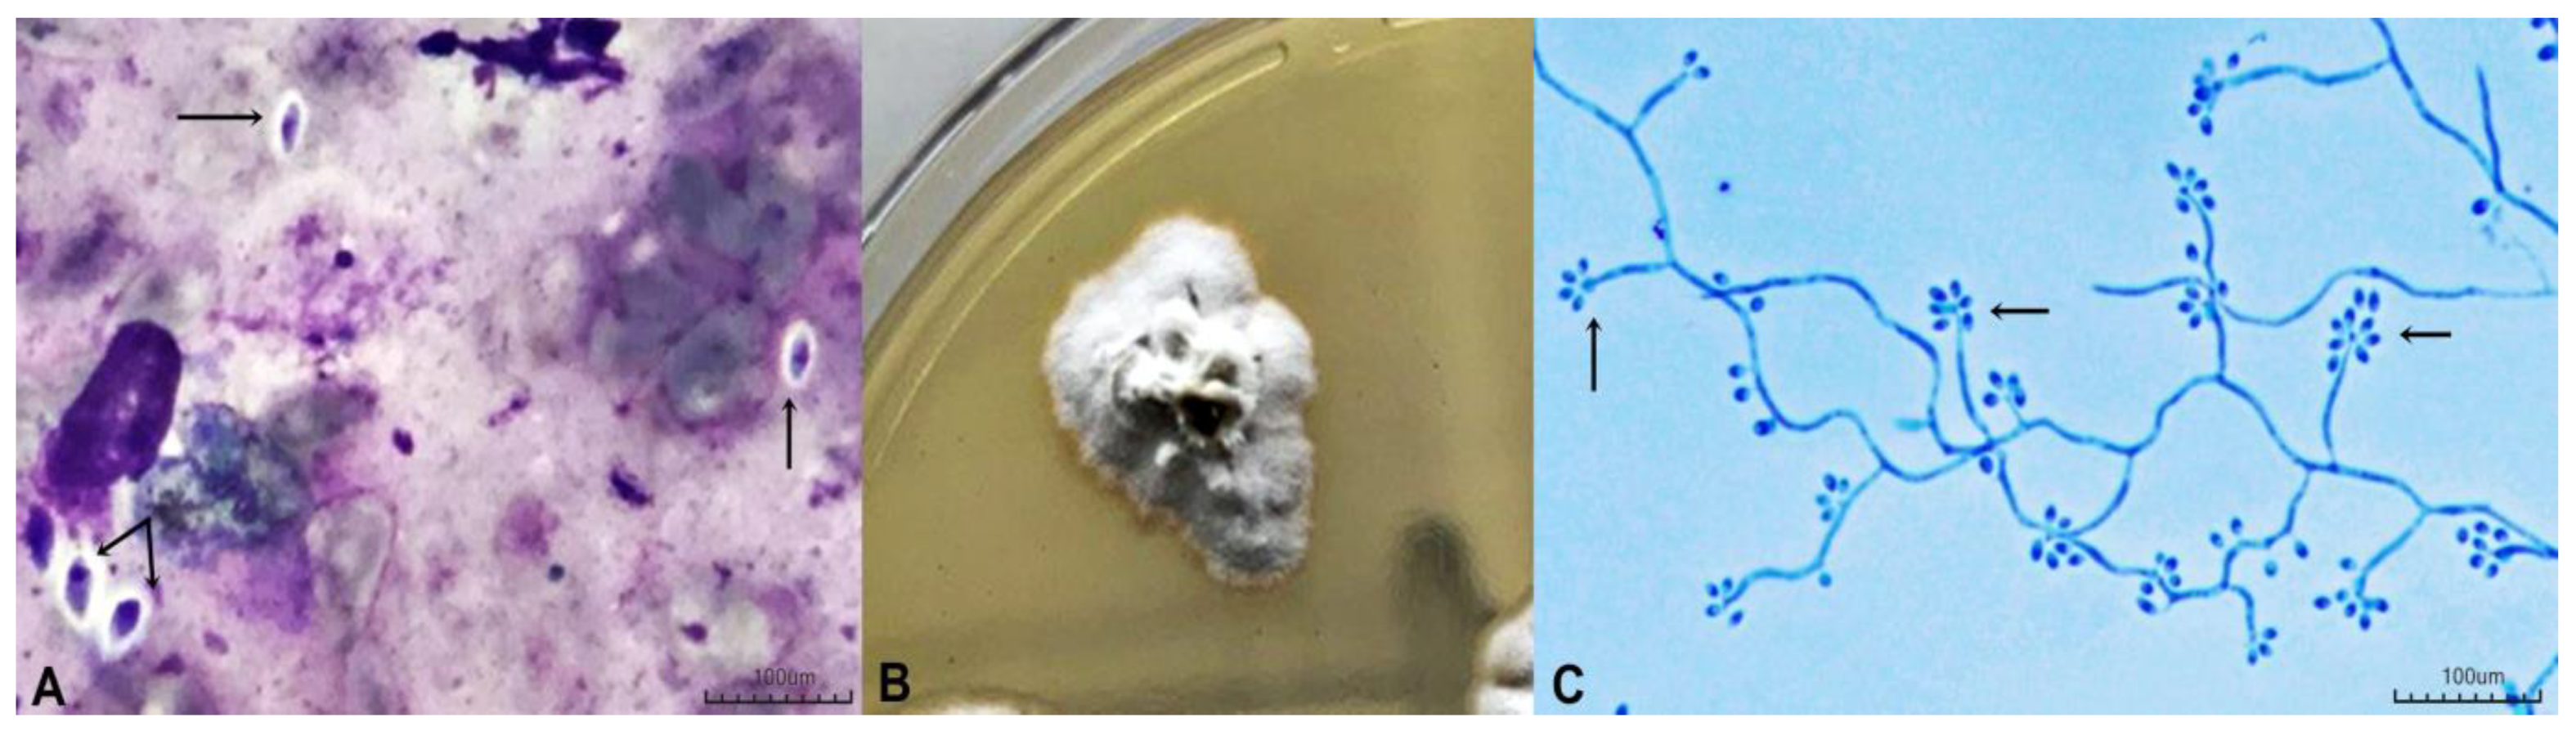

Rapid Molecular Diagnosis of Sporotrichosis Directly from Biological Samples from a Reference Center in Brazil
Abstract
1. Introduction
2. Methods
2.1. Sample Collection and Classical Mycological Diagnosis
2.2. DNA Extraction and Quantification from Clinical Samples and Strains
2.3. Molecular Identification by Partial Sequencing of Calmodulin
2.4. Nested PCR for Clinical Samples
2.5. Ethical Aspects
3. Results
4. Discussion
5. Conclusions
Author Contributions
Funding
Institutional Review Board Statement
Informed Consent Statement
Data Availability Statement
Acknowledgments
Conflicts of Interest
References
- De Oliveira-Bento, A.; de Sena Costa, A.S.; Lima, S.L.; do Monte Alves, M.; de Azevedo Melo, A.S.; Rodrigues, A.M.; da Silva-Rocha, W.P.; Milan, E.P.; Chaves, G.M. The spread of cat-transmitted sporotrichosis due to Sporothrix brasiliensis in Brazil towards the Northeast region. PLoS Negl. Trop. Dis. 2021, 15, 0009693. [Google Scholar] [CrossRef] [PubMed]
- Mora-Montes, H.M. Special Issue “Sporothrix and Sporotrichosis 2.0”. J. Fungi 2022, 8, 821. [Google Scholar] [CrossRef] [PubMed]
- França, H.E.P.; da Silva, K.C.T.; da Silva, K.E.; de Sousa, B.R.; Júnior, J.B.O. Situação epidemiológica da esporotricose humana no nordeste brasileiro. Revista Eletrônica Estácio Recife. 2022, 8, 1. [Google Scholar]
- Silva, C.E.; Valeriano, C.A.; Ferraz, C.E.; Neves, R.P.; Oliveira, M.M.; Silva, J.C.; Magalhães, V.; Lima-Neto, R.G. Epidemiological features and geographical expansion of sporotrichosis in the state of Pernambuco, northeastern Brazil. Future Microbiol. 2021, 16, 1371–1379. [Google Scholar] [CrossRef] [PubMed]
- PENAMBUCO. Secretaria Executiva de Vigilância em Saúde. Boletim Epidemiológico Esporotricose Humana. Nº01/2021. Available online: https://www.cievspe.com/_files/ugd/3293a8_7c6f315e94e04669adcf587b3c6ea944.pdf (accessed on 8 November 2023).
- Oliveira, M.M.E.; Muniz, M.d.M.; Almeida-Paes, R.; Zancope-Oliveira, R.M.; Freitas, A.D.; Lima, M.A.; Gutierrez-Galhardo, M.C.; Freitas, D.F.S. Cerebrospinal fluid PCR: A new approach for the diagnosis of CNS sporotrichosis. PLoS Negl. Trop. Dis. 2020, 14, e0008196. [Google Scholar] [CrossRef] [PubMed]
- DE Carolis, E.; Posteraro, B.; Sanguinetti, M. Old and New Insights into Sporothrix schenckii Complex Biology and Identification. Pathogens 2022, 11, 297. [Google Scholar] [CrossRef] [PubMed]
- Luiz, R.L.F.; Menezes, R.C.; Pereira, S.A.; de Vasconcellos Carvalhaes de Oliveira, R.; Oliveira1, M.M.E. Nested PCR for the Diagnosis of Feline Sporotrichosis From Formalin-Fixed and Paraffin-Embedded Samples Using Different DNA Extraction Protocols. Front. Vet. Sci. 2021, 5, 755897. [Google Scholar] [CrossRef] [PubMed]
- Hu, S.; Chung, W.-H.; Hung, S.-I.; Ho, H.-C.; Wang, Z.-W.; Chen, C.-H.; Lu, S.-C.; Kuo, T.-T.; Hong, H.-S. Detection of Sporothrix schenckii in clinical samples by a nested PCR assay. J. Clin. Microbiol. 2003, 41, 1414–1418. [Google Scholar] [CrossRef] [PubMed]
- Lima-Neto, R.G.; Neta, M.S.; Valeriano, C.A.; Neves, R.P.; Lacerda, A.M.; Ferraz, C.E.; Inácio, C.P.; Le Pape, P.; Ourliac-Garnier, I.; Faria, A.R.; et al. Antifungal efficacy of imidazo[1,2-a]pyrazine-based thiosemicarbazones and thiazolidinediones against Sporothrix species. Futur. Microbiol. 2023, 18, 1225–1233. [Google Scholar] [CrossRef]
- Orofino-Costa, R.; de Macedo, P.M.; Rodrigues, A.M.; Bernardes-Engemann, A.R. Sporotrichosis: An update on epidemiology, etiopathogenesis, laboratory and clinical therapeutics. An. Bras. de Dermatol. 2017, 92, 606–620. [Google Scholar] [CrossRef] [PubMed]
- Barros, M.B.; de Almeida Paes, R.; Schubach, A.O. Sporothrix schenckii and Sporotrichosis. Clin. Microbiol. Rev. 2011, 24, 633–654. [Google Scholar] [CrossRef] [PubMed]
- Maubon, D.; Garnaud, C.; Ramarozatovo, L.S.; Fahafahantsoa, R.R.; Cornet, M.; Rasamoelina, T. Molecular Diagnosis of Two Major Implantation Mycoses: Chromoblastomycosis and Sporotrichosis. J. Fungi 2022, 8, 382. [Google Scholar] [CrossRef] [PubMed]
- Rodrigues, A.M.; de Hoog, G.S.; Camargo, Z.P. Molecular Diagnosis of Pathogenic Sporothrix Species. PLoS Negl. Trop. Dis. 2015, 9, e0004190. [Google Scholar] [CrossRef] [PubMed]
- Zhang, M.; Li, F.; Li, R.; Gong, J.; Zhao, F. Fast diagnosis of sporotrichosis caused by Sporothrix globosa, Sporothrix schenckii, and Sporothrix brasiliensis based on multiplex real-time PCR. PLoS Negl. Trop. Dis. 2019, 13, e0007219. [Google Scholar] [CrossRef] [PubMed]
- Oliveira, M.M.E.; Almeida-Paes, R.; Gutierrez-Galhardo, M.C.; Zancope-Oliveira, R.M. Molecular identification of the Sporothrix schenckii complex. Rev. Iberoam. De Micol. 2014, 31, 2–6. [Google Scholar] [CrossRef]
- Orofino-Costa, R.; Freitasc, D.F.S.; Bernardes-Engemanna, A.R.; Rodriguesd, A.M.; Talharie, C.; Ferrazf, C.E.; Veasey, J.V.; Quintellac, L.; de Sousah, M.S.L.A.; Vettorato, R.; et al. Esporotricose humana: Recomendações da Sociedade Brasileira de Dermatologia para o manejo clínico, diagnóstico e terapêutico. An. Bras. Dermatol. 2022, 97, 757–777. [Google Scholar] [CrossRef]
- Neto, F.S.; Gadelha, C.; Silva, L.; Pazos, N.; Silva, A.; Silva, M.; Sousa, B.; Dulgheroff, A.C.B.; Guerra, F.; da Silveira, V.M.; et al. Case Report: Ocular Sporotrichosis—A Seven-Case Series. Am. J. Trop. Med. Hyg. 2023, 108, 1109–1114. [Google Scholar] [CrossRef] [PubMed]
- Falcão, E.M.M.; Pires, M.C.D.S.; Andrade, H.B.; Gonçalves, M.L.C.; Almeida-Paes, R.; Valle, A.C.F.D.; Bastos, F.I.; Gutierrez-Galhardo, M.C.; Freitas, D.F.S. Zoonotic sporotrichosis with greater severity in Rio de Janeiro, Brazil: 118 hospitalizations and 11 deaths in the last 2 decades in a reference institution. Med. Mycol. 2019, 58, 141–143. [Google Scholar] [CrossRef]
- Hayashi, S.; Kaminaga, T.; Baba, A.; Koike, S.; Koike, M.; Kanno, M.; Ishikawa, S.; Tsukada, K.; Suzuki, T.; Hamasaki, Y.; et al. Diagnostic value of a nested polymerase chain reaction for diagnosing cutaneous sporotrichosis from paraffin-embedded skin tissue. Mycoses 2019, 62, 1148–1153. [Google Scholar] [CrossRef] [PubMed]

| Sample ID. | AGE | SEX | Occupation | Clinical Form | Comorbidity | Sample Topography | Sample Type | Direct Exam * | Culture | Cal Gene | Nested PCR |
|---|---|---|---|---|---|---|---|---|---|---|---|
| HC100/2023 | 55 | Fem. | Housekeeper | Parinaud oculoglandular syndrome | SAH | Left conjunctiva | Conjunctival secretion | Negative | Sporothrix spp. | S. brasiliensis | Sporothrix sensu lato |
| HC141/2023 | 64 | Male | Freelancer salesman | Disseminated sporotrichosis | SAH | Left lower limb | Tissue fragment | Negative | Sporothrix spp. | S. brasiliensis | Sporothrix sensu lato |
| HC201/2023 | 44 | Fem. | Housewife | Fixed sporotrichosis | SAH | Malar | Lesion exudate | Unrealized | Sporothrix spp. | S. brasiliensis | Sporothrix sensu lato |
| HC204/2023 | 37 | Male | Programmer | Fixed sporotrichosis | Does not have | Right lower limb | Lesion exudate | Positive | Sporothrix spp. | S. brasiliensis | Sporothrix sensu lato |
| HC212/2023 | 48 | Fem. | Housewife | Fixed sporotrichosis | Does not have | Right forearm | Tissue fragment | Unrealized | Sporothrix spp. | S. brasiliensis | Sporothrix sensu lato |
| HC237/2023 | 56 | Male | Unemployed | Disseminated sporotrichosis | HIV | Conjunctiva | Conjunctival secretion | Unrealized | Sporothrix spp. | S. brasiliensis | Sporothrix sensu lato |
| HC256//2023 | 17 | Male | Student | Not included | Does not have | Right hand | Tissue fragment | Unrealized | Sporothrix spp. | S. brasiliensis | Sporothrix sensu lato |
| HC262/2023 | 4 | Fem. | Student | Parinaud oculoglandular syndrome | Does not have | Left conjunctiva | Lesion exudate | Unrealized | Sporothrix spp. | S. brasiliensis | Sporothrix sensu lato |
| HC264/2023 | 45 | Male | Driver | Lymphocutaneous | SAH | Right forearm | Tissue fragment | Unrealized | Sporothrix spp. | S. brasiliensis | Sporothrix sensu lato |
| HC305/2023 | 47 | Male | Unemployed | Disseminated sporotrichosis | HIV | Back | Tissue fragment | Positive | Sporothrix spp. | S. brasiliensis | Sporothrix sensu lato |
| HC312/2023 | 33 | Male | Driver | Lymphocutaneous | Does not have | Right forearm | Tissue fragment | Negative | Sporothrix spp. | S. brasiliensis | Sporothrix sensu lato |
| HC313/2023 | 33 | Fem. | Housewife | Disseminated sporotrichosis | HIV | Right forearm | Tissue fragment | Positive | Sporothrix spp. | S. brasiliensis | Sporothrix sensu lato |
| Neck | Lesion exudate | Negative | Absence of fungal growth | Unrealized | Sporothrix sensu lato |
Disclaimer/Publisher’s Note: The statements, opinions and data contained in all publications are solely those of the individual author(s) and contributor(s) and not of MDPI and/or the editor(s). MDPI and/or the editor(s) disclaim responsibility for any injury to people or property resulting from any ideas, methods, instructions or products referred to in the content. |
© 2024 by the authors. Licensee MDPI, Basel, Switzerland. This article is an open access article distributed under the terms and conditions of the Creative Commons Attribution (CC BY) license (https://creativecommons.org/licenses/by/4.0/).
Share and Cite
da Silva, A.G.; de Matos, A.F.C.; de Sousa, B.R.; Ferraz, C.E.; Luiz, R.L.F.; Neves, R.P.; Lima-Neto, R.G.d.; Oliveira, M.M.E. Rapid Molecular Diagnosis of Sporotrichosis Directly from Biological Samples from a Reference Center in Brazil. J. Fungi 2024, 10, 432. https://doi.org/10.3390/jof10060432
da Silva AG, de Matos AFC, de Sousa BR, Ferraz CE, Luiz RLF, Neves RP, Lima-Neto RGd, Oliveira MME. Rapid Molecular Diagnosis of Sporotrichosis Directly from Biological Samples from a Reference Center in Brazil. Journal of Fungi. 2024; 10(6):432. https://doi.org/10.3390/jof10060432
Chicago/Turabian Styleda Silva, Amanda Gabriela, Arthur Felipe Cavalcanti de Matos, Bruna Rodrigues de Sousa, Claudia Elise Ferraz, Raul Leal Faria Luiz, Rejane Pereira Neves, Reginaldo Gonçalves de Lima-Neto, and Manoel Marques Evangelista Oliveira. 2024. "Rapid Molecular Diagnosis of Sporotrichosis Directly from Biological Samples from a Reference Center in Brazil" Journal of Fungi 10, no. 6: 432. https://doi.org/10.3390/jof10060432
APA Styleda Silva, A. G., de Matos, A. F. C., de Sousa, B. R., Ferraz, C. E., Luiz, R. L. F., Neves, R. P., Lima-Neto, R. G. d., & Oliveira, M. M. E. (2024). Rapid Molecular Diagnosis of Sporotrichosis Directly from Biological Samples from a Reference Center in Brazil. Journal of Fungi, 10(6), 432. https://doi.org/10.3390/jof10060432

